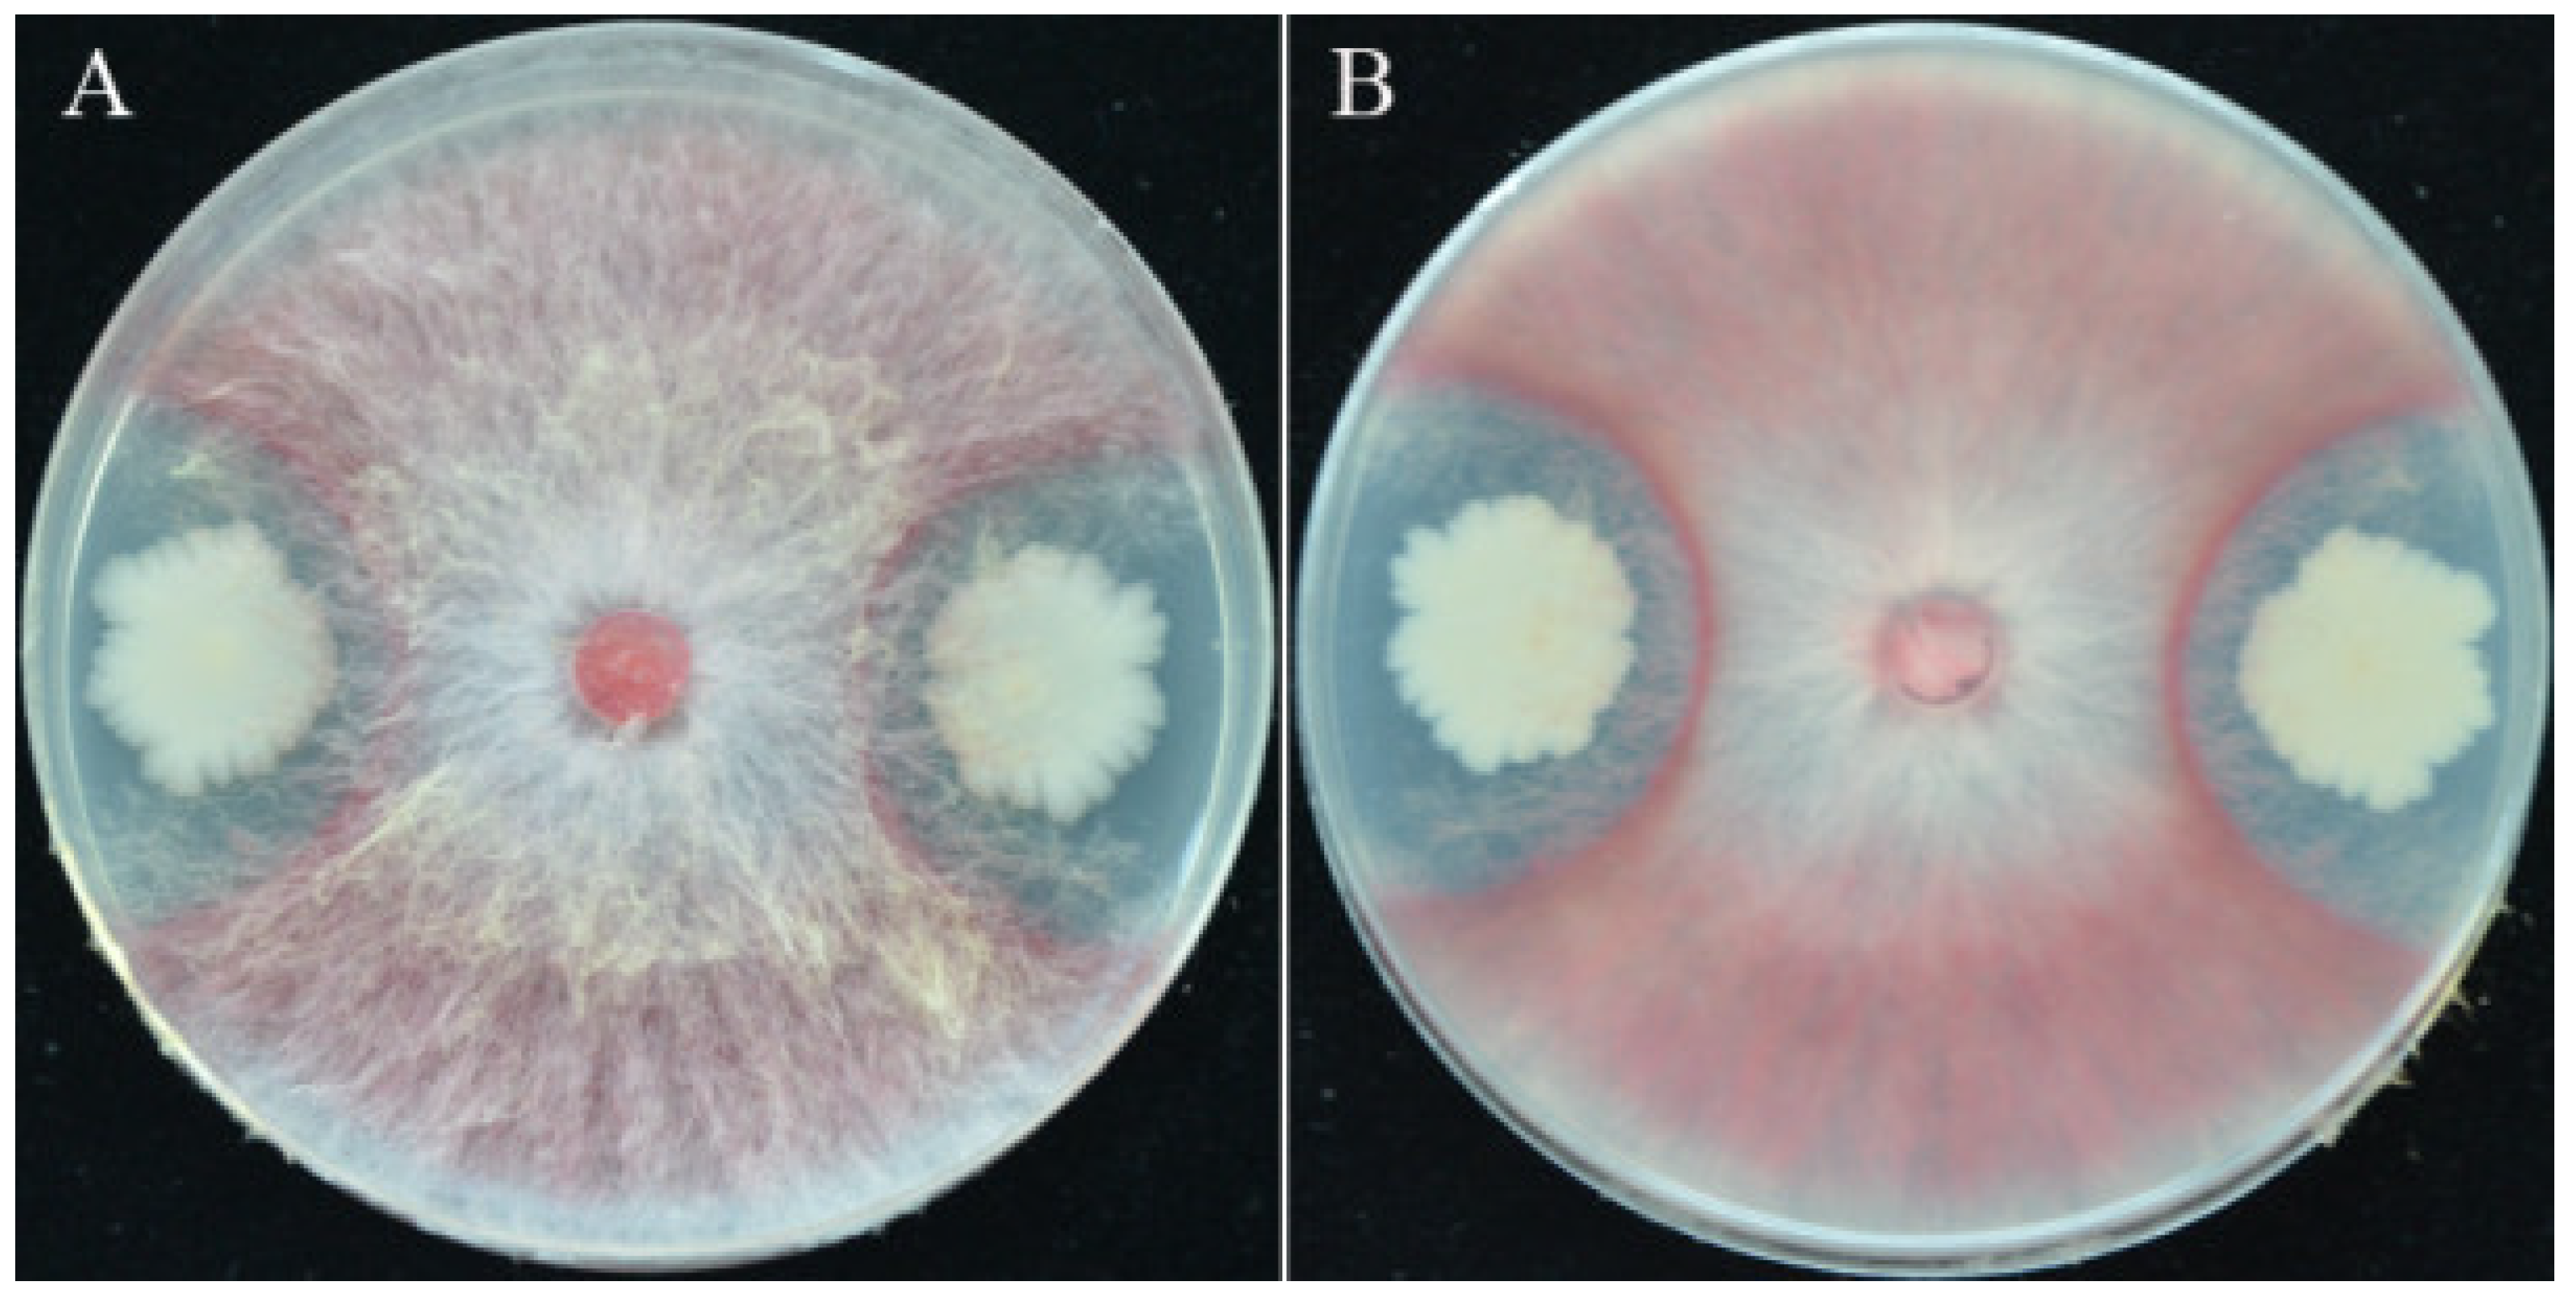
Biology 11 00778 g001 550
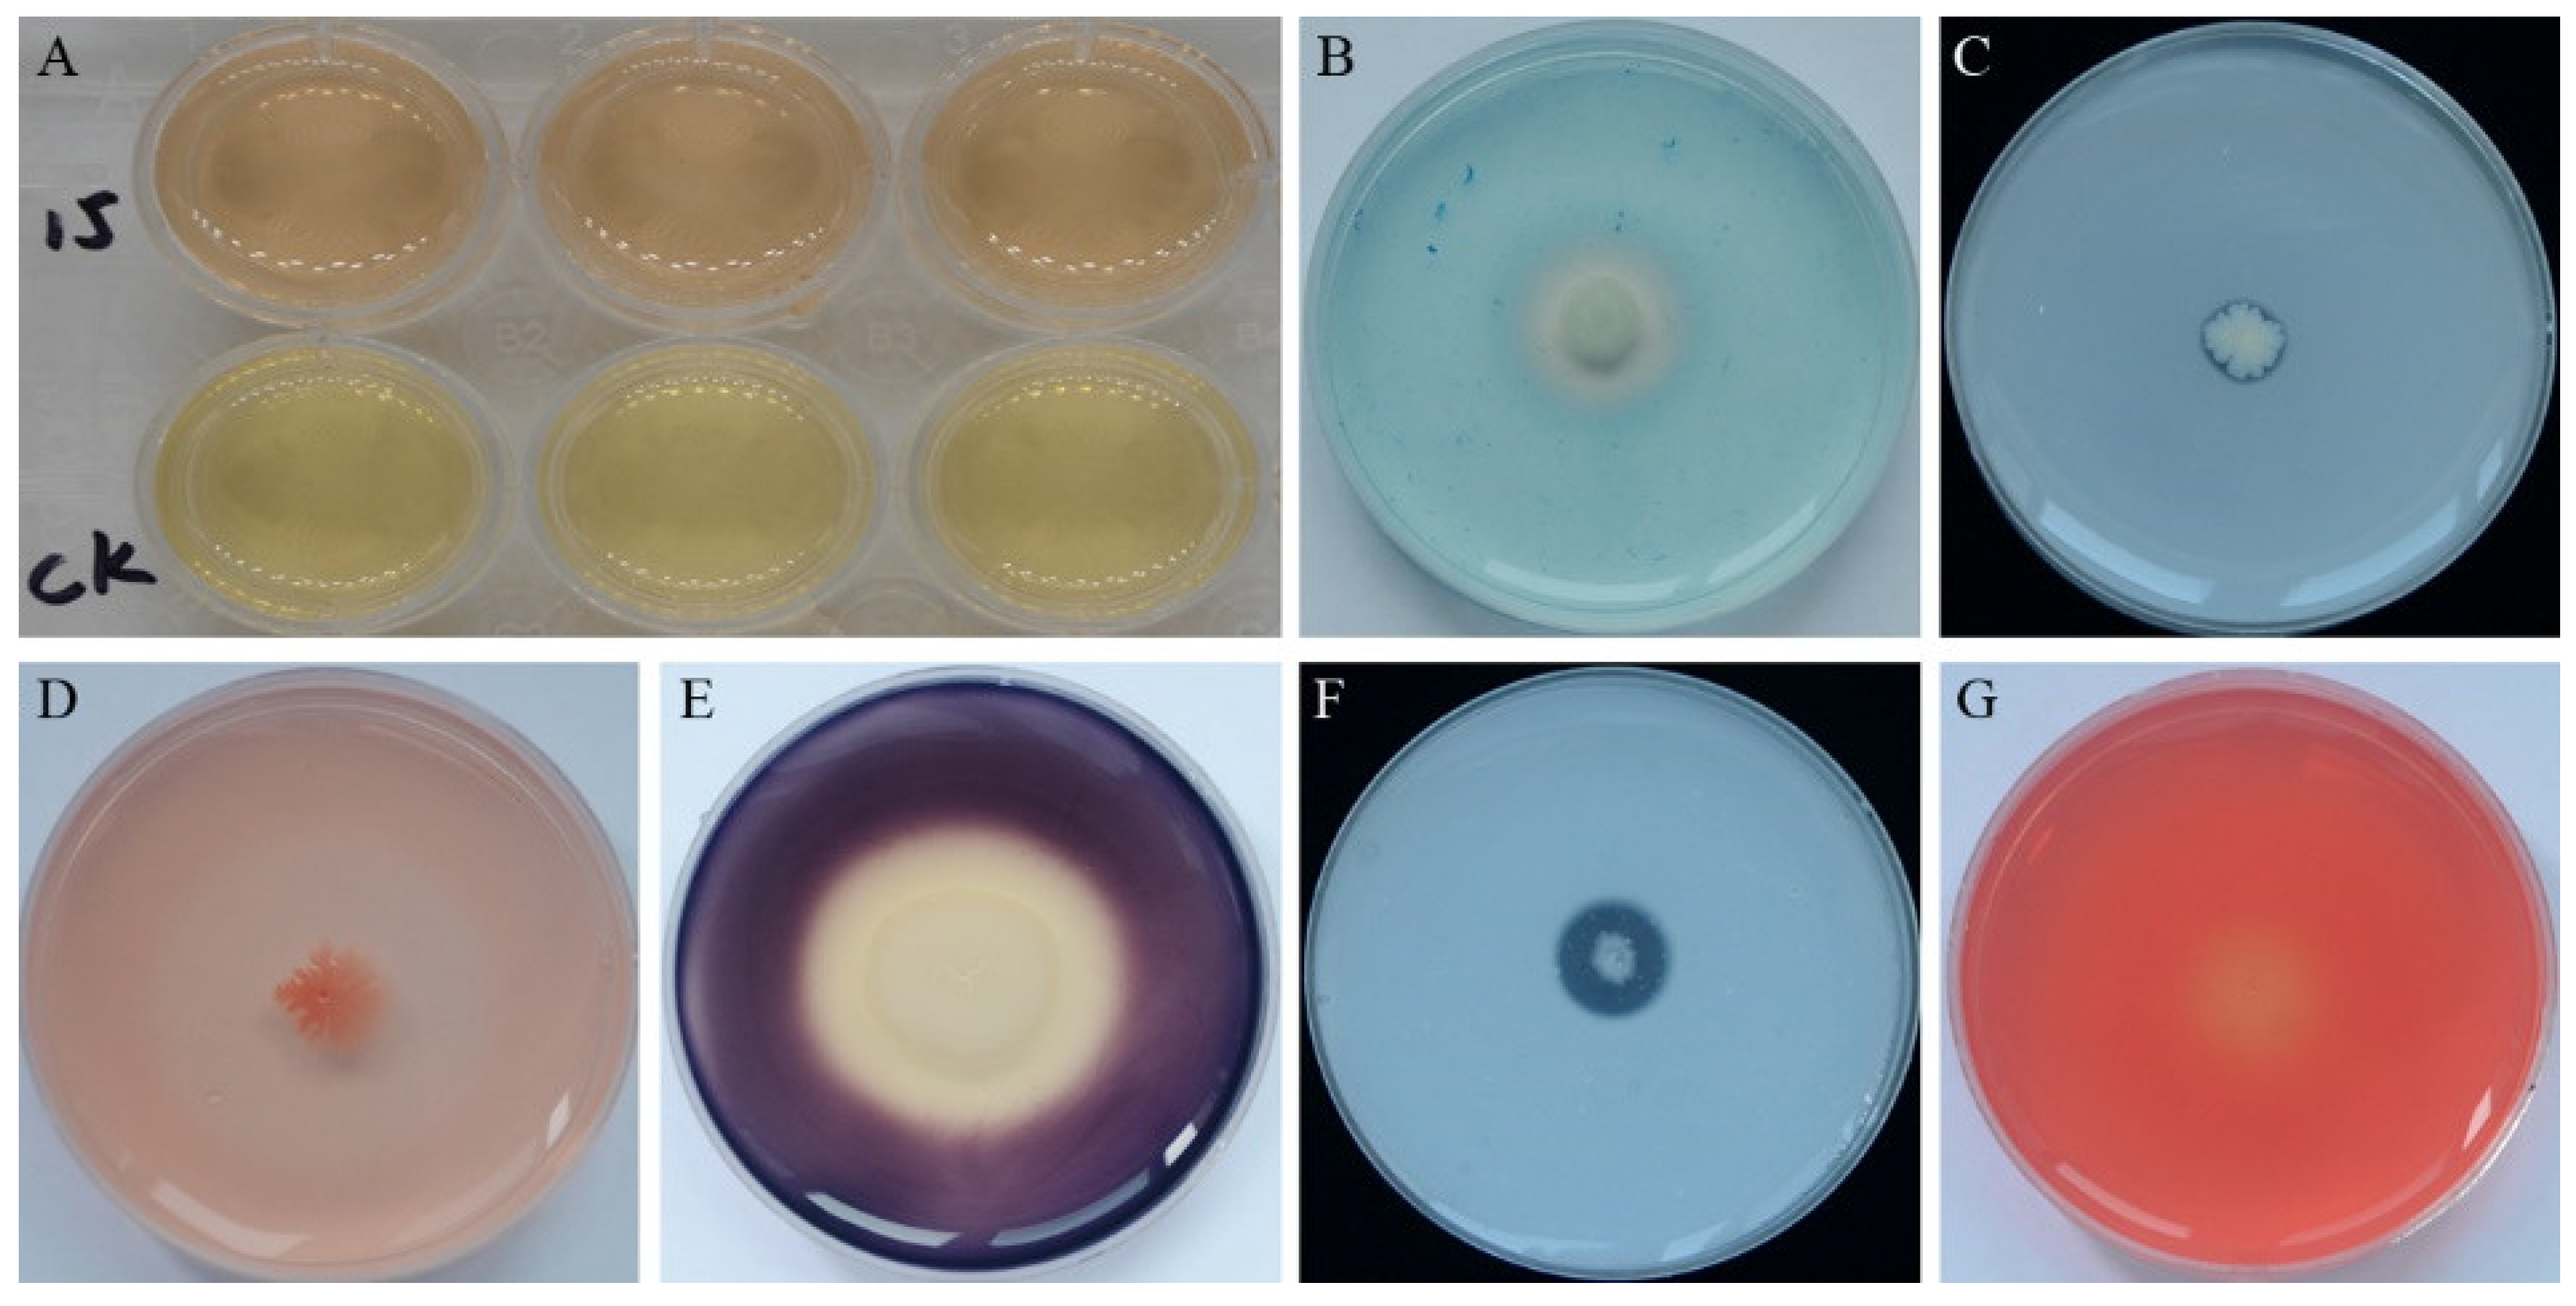
Biology 11 00778 g002 550

Genomic and Phenotypic Insights into the Potential of Bacillus subtilis YB-15 Isolated from Rhizosphere to Biocontrol against Crown Rot and Promote Growth of Wheat
Abstract
:Simple Summary
Abstract
1. Introduction
2. Materials and Methods
2.1. Bacteria and Pathogens Used in this Study
2.2. Detection of In Vitro Plant Growth Promotion and Biocontrol Traits
2.3. Growth Promotion and Biocontrol Assay of Strain YB-15 against Fusarium Crown Rot of Wheat Seedlings
2.4. Wheat Defense-Related Enzyme Activities
2.5. DNA Preparation, Genome Sequencing, Assembly and Annotation of Strain YB-15
2.6. Molecular Identification of Strain YB-15
2.7. Analysis of CAZymes and Genes Associated with Growth Promotion and Secondary Metabolites of Strain YB-15
2.8. Statistical Analysis
3. Results
3.1. Isolation of Strain YB-15 and Its Antagonism against F. pseudograminearum
3.2. Plant Growth Promotion and Antifungal Traits of Strain YB-15 in Culture
3.3. Effects of Strain YB-15 on Fusarium Crown Rot of Wheat Seedlings
3.4. Growth Promotion of Wheat Seedlings by Strain YB-15
3.5. Defense-Related Enzyme Activities of Wheat Seedlings
3.6. Genome Assembly and Annotation of Strain YB-15
3.7. Species Identification of Strain YB-15
3.8. Predicted Genes for CAZymes
3.9. Predicted Genes for Secondary Metabolites
3.10. Predicted Genes for Plant Growth Promotion
4. Discussion
5. Conclusions
Supplementary Materials
Author Contributions
Funding
Institutional Review Board Statement
Informed Consent Statement
Data Availability Statement
Conflicts of Interest
References
- Alomari, D.Z.; Eggert, K.; von Wiren, N.; Alqudah, A.M.; Polley, A.; Plieske, J.; Ganal, M.W.; Pillen, K.; Roder, M.S. Identifying Candidate Genes for Enhancing Grain Zn Concentration in Wheat. Front. Plant Sci. 2018, 9, 1313. [Google Scholar] [CrossRef] [PubMed]
 - Moya, E. Fusarium crown rot disease: Biology, interactions, management and function as a possible sensor of global climate change. Cienc. E Investig. Agrar. Rev. Latinoam. Cienc. Agric. 2013, 40, 235–252. [Google Scholar]
 - Kazan, K.; Gardiner, D.M. Fusarium crown rot caused by Fusarium pseudograminearum in cereal crops: Recent progress and future prospects. Mol. Plant Pathol. 2018, 19, 1547–1562. [Google Scholar] [CrossRef] [PubMed] [Green Version]
 - Nicolopoulou-Stamati, P.; Maipas, S.; Kotampasi, C.; Stamatis, P.; Hens, L. Chemical Pesticides and Human Health: The Urgent Need for a New Concept in Agriculture. Front. Public Health 2016, 4, 148. [Google Scholar] [CrossRef] [PubMed] [Green Version]
 - Sardar, M.F.; Abbas, T.; Naveed, M.; Siddique, S.; Mustafa, A.; Abbasi, B.; Khan, K. Biopesticides: Importance and Challenges; Apple Academic Press: Palm Bay, FL, USA, 2021; pp. 129–151. [Google Scholar]
 - Dehghanpour-Farashah, S.; Taheri, P.; Falahati-Rastegar, M. Effect of polyamines and nitric oxide in Piriformospora indica-induced resistance and basal immunity of wheat against Fusarium pseudograminearum. Biol. Control. 2019, 136, 104006. [Google Scholar] [CrossRef]
 - Kim, Y.T.; Monkhung, S.; Lee, Y.S.; Kim, K.Y. Effects of Lysobacter antibioticus HS124, an effective biocontrol agent against Fusarium graminearum, on crown rot disease and growth promotion of wheat. Can. J. Microbiol. 2019, 65, 904–912. [Google Scholar] [CrossRef]
 - Winter, M.; Samuels, P.L.; Otto-Hanson, L.K.; Dill-Macky, R.; Kinkel, L.L. Biological control of Fusarium crown and root rot of wheat by Streptomyces isolates—It’s complicated. Phytobiomes J. 2019, 3, 52–60. [Google Scholar] [CrossRef] [Green Version]
 - O’Sullivan, C.A.; Roper, M.M.; Myers, C.A.; Thatcher, L.F. Developing Actinobacterial Endophytes as Biocontrol Products for Fusarium pseudograminearum in Wheat. Front. Bioeng. Biotechnol. 2021, 9, 691770. [Google Scholar] [CrossRef]
 - Kumar, P.; Dubey, R.C.; Maheshwari, D.K. Bacillus strains isolated from rhizosphere showed plant growth promoting and antagonistic activity against phytopathogens. Microbiol. Res. 2012, 167, 493–499. [Google Scholar] [CrossRef]
 - Miljakovic, D.; Marinkovic, J.; Balesevic-Tubic, S. The Significance of Bacillus spp. in Disease Suppression and Growth Promotion of Field and Vegetable Crops. Microorganisms 2020, 8, 1037. [Google Scholar] [CrossRef]
 - Blake, C.; Christensen, M.N.; Kovacs, A.T. Molecular Aspects of Plant Growth Promotion and Protection by Bacillus subtilis. Mol. Plant Microbe Interact. 2021, 34, 15–25. [Google Scholar] [CrossRef] [PubMed]
 - Ali, M.A.; Naveed, M.; Mustafa, A.; Abbas, A. The Good, the Bad, and the Ugly of Rhizosphere Microbiome. In Probiotics and Plant Health; Kumar, V., Kumar, M., Sharma, S., Prasad, R., Eds.; Springer: Singapore, 2017; pp. 253–290. [Google Scholar]
 - Xu, W.; Zhang, L.; Goodwin, P.H.; Xia, M.; Zhang, J.; Wang, Q.; Liang, J.; Sun, R.; Wu, C.; Yang, L. Isolation, Identification, and Complete Genome Assembly of an Endophytic Bacillus velezensis YB-130, Potential Biocontrol Agent Against Fusarium graminearum. Front. Microbiol. 2020, 11, 598285. [Google Scholar] [CrossRef] [PubMed]
 - Saeed, Q.; Xiukang, W.; Haider, F.U.; Kučerik, J.; Mumtaz, M.Z.; Holatko, J.; Naseem, M.; Kintl, A.; Ejaz, M.; Naveed, M.; et al. Rhizosphere Bacteria in Plant Growth Promotion, Biocontrol, and Bioremediation of Contaminated Sites: A Comprehensive Review of Effects and Mechanisms. Int. J. Mol. Sci. 2021, 22, 10529. [Google Scholar] [CrossRef] [PubMed]
 - Chanway, C.P.; Nelson, L.M.; Holl, F.B. Cultivar-specific growth promotion of spring wheat (Triticum aestivum L.) by coexistent Bacillus species. Can. J. Microbiol. 1988, 34, 925–929. [Google Scholar] [CrossRef]
 - Ku, Y.; Xu, G.; Tian, X.; Xie, H.; Yang, X.; Cao, C.; Chen, Y. Root colonization and growth promotion of soybean, wheat and Chinese cabbage by Bacillus cereus YL6. PLoS ONE 2018, 13, e0200181. [Google Scholar] [CrossRef] [Green Version]
 - Rojas Padilla, J.; Chaparro Encinas, L.A.; Robles Montoya, R.I.; de los Santos Villalobos, S. Growth promotion on wheat (Triticum turgidum L. subsp. durum) by co-inoculation of native Bacillus strains isolated from the Yaqui Valley, Mexico. Nova Scientia 2020, 12, 1–27. [Google Scholar] [CrossRef]
 - Sasani, m.; Ahmadzadeh, M. Evaluation of antagonistic effect of several strain of Bacillus bacteria on control of crown and root rot of wheat with Fusarium pseudograminearum. Biol. Control Pests Plant Dis. 2021, 9, 115–126. [Google Scholar] [CrossRef]
 - Carlson, R.; Tugizimana, F.; Steenkamp, P.A.; Dubery, I.A.; Hassen, A.I.; Labuschagne, N. Rhizobacteria-induced systemic resilience in Sorghum bicolor (L.) moench against Fusarium pseudograminearum crown rot under drought stress conditions. Biol. Control 2020, 151, 104395. [Google Scholar] [CrossRef]
 - Wu, J.J.; Chou, H.P.; Huang, J.W.; Deng, W.L. Genomic and biochemical characterization of antifungal compounds produced by Bacillus subtilis PMB102 against Alternaria brassicicola. Microbiol. Res. 2021, 251, 126815. [Google Scholar] [CrossRef]
 - Kiesewalter, H.T.; Lozano-Andrade, C.N.; Wibowo, M.; Strube, M.L.; Maroti, G.; Snyder, D.; Jorgensen, T.S.; Larsen, T.O.; Cooper, V.S.; Weber, T.; et al. Genomic and Chemical Diversity of Bacillus subtilis Secondary Metabolites against Plant Pathogenic Fungi. mSystems 2021, 6, e00770-20. [Google Scholar] [CrossRef]
 - Franco-Sierra, N.D.; Posada, L.F.; Santa-Maria, G.; Romero-Tabarez, M.; Villegas-Escobar, V.; Alvarez, J.C. Bacillus subtilis EA-CB0575 genome reveals clues for plant growth promotion and potential for sustainable agriculture. Funct. Integr. Genom. 2020, 20, 575–589. [Google Scholar] [CrossRef] [PubMed]
 - Yang, L.; Quan, X.; Xue, B.; Goodwin, P.H.; Lu, S.; Wang, J.; Du, W.; Wu, C. Isolation and identification of Bacillus subtilis strain YB-05 and its antifungal substances showing antagonism against Gaeumannomyces graminis var. tritici. Biol. Control 2015, 85, 52–58. [Google Scholar] [CrossRef]
 - Glickmann, E.; Dessaux, Y. A critical examination of the specificity of the Salkowski reagent for indolic compounds produced by phytopathogenic bacteria. Appl. Environ. Microbiol. 1995, 61, 793–796. [Google Scholar] [CrossRef] [PubMed] [Green Version]
 - Schwyn, B.; Neilands, J.B. Universal chemical assay for the detection and determination of siderophores. Anal. Biochem. 1987, 160, 47–56. [Google Scholar] [CrossRef]
 - Chen, Q.; Liu, S. Identification and Characterization of the Phosphate-Solubilizing Bacterium Pantoea sp. S32 in Reclamation Soil in Shanxi, China. Front. Microbiol. 2019, 10, 2171. [Google Scholar] [CrossRef] [PubMed] [Green Version]
 - Teather, R.M.; Wood, P.J. Use of Congo red-polysaccharide interactions in enumeration and characterization of cellulolytic bacteria from the bovine rumen. Appl. Environ. Microbiol. 1982, 43, 777–780. [Google Scholar] [CrossRef] [Green Version]
 - Al-Naamani, L.S.H.; Dobretsov, S.; Al-Sabahi, J.; Soussi, B. Identification and characterization of two amylase producing bacteria Cellulosimicrobium sp. and Demequina sp. isolated from marine organisms. J. Agric. Mar. Sci. [JAMS] 2015, 20, 8–15. [Google Scholar]
 - Kazanas, N. Proteolytic activity of microorganisms isolated from freshwater fish. Appl. Microbiol. 1968, 16, 128–132. [Google Scholar] [CrossRef]
 - Zhang, J.; Wang, L.M.; Li, Y.H.; Ding, S.L.; Yuan, H.X.; Riley, I.T.; Li, H.L. Biocontrol of cereal cyst nematode by Streptomyces anulatus isolate S07. Australas. Plant Pathol. 2016, 45, 57–64. [Google Scholar] [CrossRef]
 - Xu, W.; Zhao, F.; Deng, X.; Goodwin, P.; Xia, M.; Zhang, J.; Sun, R.; Liang, J.; Wu, C.; Yang, L. First Report of Collar Canker and Dieback of Camellia sinensis caused by Fusarium solani Species Complex in Henan, China. Plant Dis. 2022; Online ahead of print. [Google Scholar] [CrossRef]
 - Xu, W.; Xu, L.; Deng, X.; Goodwin, P.H.; Xia, M.; Zhang, J.; Wang, Q.; Sun, R.; Pan, Y.; Wu, C.; et al. Biological Control of Take-All and Growth Promotion in Wheat by Pseudomonas chlororaphis YB-10. Pathogens 2021, 10, 903. [Google Scholar] [CrossRef]
 - Ullah, H.; Yasmin, H.; Mumtaz, S.; Jabeen, Z.; Naz, R.; Nosheen, A.; Hassan, M.N. Multitrait Pseudomonas spp. Isolated from Monocropped Wheat (Triticum aestivum) Suppress Fusarium Root and Crown Rot. Phytopathology 2020, 110, 582–592. [Google Scholar] [CrossRef] [PubMed]
 - Wick, R.R.; Judd, L.M.; Gorrie, C.L.; Holt, K.E. Unicycler: Resolving bacterial genome assemblies from short and long sequencing reads. PLoS Comput. Biol. 2017, 13, e1005595. [Google Scholar] [CrossRef] [PubMed] [Green Version]
 - Stothard, P.; Wishart, D.S. Circular genome visualization and exploration using CGView. Bioinformatics 2004, 21, 537–539. [Google Scholar] [CrossRef] [Green Version]
 - Li, H. Minimap2: Pairwise alignment for nucleotide sequences. Bioinformatics 2018, 34, 3094–3100. [Google Scholar] [CrossRef] [PubMed]
 - Li, H. Aligning sequence reads, clone sequences and assembly contigs with BWA-MEM. arXiv 2013, arXiv:1303.3997. [Google Scholar]
 - Li, H.; Handsaker, B.; Wysoker, A.; Fennell, T.; Ruan, J.; Homer, N.; Marth, G.; Abecasis, G.; Durbin, R.; 1000 Genome Project Data Processing Subgroup. The Sequence Alignment/Map format and SAMtools. Bioinformatics 2009, 25, 2078–2079. [Google Scholar] [CrossRef] [Green Version]
 - Seemann, T. Prokka: Rapid prokaryotic genome annotation. Bioinformatics 2014, 30, 2068–2069. [Google Scholar] [CrossRef]
 - Hyatt, D.; Chen, G.L.; Locascio, P.F.; Land, M.L.; Larimer, F.W.; Hauser, L.J. Prodigal: Prokaryotic gene recognition and translation initiation site identification. BMC Bioinform. 2010, 11, 119. [Google Scholar] [CrossRef] [Green Version]
 - Laslett, D.; Canback, B. ARAGORN, a program to detect tRNA genes and tmRNA genes in nucleotide sequences. Nucleic Acids Res. 2004, 32, 11–16. [Google Scholar] [CrossRef]
 - Lagesen, K.; Hallin, P.; Rodland, E.A.; Staerfeldt, H.H.; Rognes, T.; Ussery, D.W. RNAmmer: Consistent and rapid annotation of ribosomal RNA genes. Nucleic Acids Res. 2007, 35, 3100–3108. [Google Scholar] [CrossRef]
 - Yoon, S.H.; Ha, S.M.; Lim, J.; Kwon, S.; Chun, J. A large-scale evaluation of algorithms to calculate average nucleotide identity. Antonie Van Leeuwenhoek 2017, 110, 1281–1286. [Google Scholar] [CrossRef] [PubMed]
 - Zhang, H.; Yohe, T.; Huang, L.; Entwistle, S.; Wu, P.; Yang, Z.; Busk, P.K.; Xu, Y.; Yin, Y. dbCAN2: A meta server for automated carbohydrate-active enzyme annotation. Nucleic Acids Res. 2018, 46, W95–W101. [Google Scholar] [CrossRef] [PubMed] [Green Version]
 - Petersen, T.N.; Brunak, S.; von Heijne, G.; Nielsen, H. SignalP 4.0: Discriminating signal peptides from transmembrane regions. Nat. Methods 2011, 8, 785–786. [Google Scholar] [CrossRef] [PubMed]
 - Blin, K.; Shaw, S.; Steinke, K.; Villebro, R.; Ziemert, N.; Lee, S.Y.; Medema, M.H.; Weber, T. antiSMASH 5.0: Updates to the secondary metabolite genome mining pipeline. Nucleic Acids Res. 2019, 47, W81–W87. [Google Scholar] [CrossRef] [Green Version]
 - Richter, M.; Rossello-Mora, R. Shifting the genomic gold standard for the prokaryotic species definition. Proc. Natl. Acad. Sci. USA 2009, 106, 19126–19131. [Google Scholar] [CrossRef] [Green Version]
 - Caulier, S.; Nannan, C.; Gillis, A.; Licciardi, F.; Bragard, C.; Mahillon, J. Overview of the Antimicrobial Compounds Produced by Members of the Bacillus subtilis Group. Front. Microbiol. 2019, 10, 302. [Google Scholar] [CrossRef] [Green Version]
 - Khan, N.; Ali, S.; Shahid, M.A.; Mustafa, A.; Sayyed, R.Z.; Curá, J.A. Insights into the Interactions among Roots, Rhizosphere, and Rhizobacteria for Improving Plant Growth and Tolerance to Abiotic Stresses: A Review. Cells 2021, 10, 1551. [Google Scholar] [CrossRef]
 - Salwan, R.; Sharma, V. Genome wide underpinning of antagonistic and plant beneficial attributes of Bacillus sp. SBA12. Genomics 2020, 112, 2894–2902. [Google Scholar] [CrossRef]
 - Chen, L.; Heng, J.; Qin, S.; Bian, K. A comprehensive understanding of the biocontrol potential of Bacillus velezensis LM2303 against Fusarium head blight. PLoS ONE 2018, 13, e0198560. [Google Scholar] [CrossRef] [Green Version]
 - Li, Q.; Liao, S.; Wei, J.; Xing, D.; Xiao, Y.; Yang, Q. Isolation of Bacillus subtilis strain SEM-2 from silkworm excrement and characterisation of its antagonistic effect against Fusarium spp. Can. J. Microbiol. 2020, 66, 401–412. [Google Scholar] [CrossRef] [Green Version]
 - Li, Y.; Chen, S. Fusaricidin Produced by Paenibacillus polymyxa WLY78 Induces Systemic Resistance against Fusarium Wilt of Cucumber. Int. J. Mol. Sci. 2019, 20, 5240. [Google Scholar] [CrossRef] [PubMed] [Green Version]
 - Jadhav, H.; Sayyed, R. Hydrolytic enzymes of rhizospheric microbes in crop protection. MOJ Cell Sci. Rep. 2016, 3, 135–136. [Google Scholar]
 - Choudhary, D.K.; Johri, B.N. Interactions of Bacillus spp. and plants—With special reference to induced systemic resistance (ISR). Microbiol. Res. 2009, 164, 493–513. [Google Scholar] [CrossRef] [PubMed]
 - Kloepper, J.W.; Ryu, C.M.; Zhang, S. Induced Systemic Resistance and Promotion of Plant Growth by Bacillus spp. Phytopathology 2004, 94, 1259–1266. [Google Scholar] [CrossRef] [Green Version]
 - Scavino, A.F.; Pedraza, R.O. The role of siderophores in plant growth-promoting bacteria. In Bacteria in Agrobiology: Crop Productivity; Springer: New York, NY, USA, 2013; pp. 265–285. [Google Scholar]

| Treatments | Disease Incidence (%) | Disease Index | Control Efficacy (%) | 
|---|---|---|---|
| FPS | 91.67 ± 1.67 a | 2.63 ± 0.03 a | |
| FPS + YB-15 | 15.00 ± 2.89 b | 0.48 ± 0.02 b | 81.50 ± 0.76 | 
| Treatments | Shoot Height (cm) | Root Length (cm) | Root Fresh Weight (g) | Shoot Fresh Weight (g) | 
|---|---|---|---|---|
| CK | 27.98 ± 0.76 a | 8.74 ± 1.11 a | 1.05 ± 0.02 b | 5.32 ± 0.06 b | 
| YB-15 | 28.33 ± 0.77 a | 8.87 ± 0.97 a | 1.17 ± 0.03 a | 5.54 ± 0.03 a | 
| FPS | 25.52 ± 2.73 b | 7.1 ± 0.98 b | 0.56 ± 0.03 d | 4.01 ± 0.03 d | 
| FPS + YB-15 | 27.7 ± 0.79 a | 8.96 ± 1.39 a | 0.94 ± 0.02 c | 4.56 ± 0.04 c | 
| Treatments | LOX (U/g) | PAL (U/g) | CAT (U/g) | PPO (U/g) | POD (U/g) | 
|---|---|---|---|---|---|
| CK | 574.76 ± 4.48 c | 28.57 ± 0.54 d | 213.07 ± 1.39 d | 22.25 ± 0.87 d | 8173.10 ± 47.64 d | 
| YB-15 | 733.42 ± 7.04 c | 32.30 ± 0.74 c | 274.24 ± 0.90 c | 32.98 ± 0.90 c | 14,955.53 ± 131.38 b | 
| FPS | 6581.31 ± 72.21 b | 34.64 ± 0.55 b | 373.10 ± 1.21 b | 41.61 ± 0.82 b | 8657.33 ± 47.98 c | 
| FPS + YB-15 | 7457.08 ± 69.68 a | 41.61 ± 0.60 a | 597.35 ± 0.96 a | 49.71 ± 0.89 a | 12,425.40 ± 172.51 a | 
| Clusters | Types | From | To | Most Similar Known Clusters | Similarity | 
|---|---|---|---|---|---|
| Cluster 1 | NRPS | 359,999 | 423,558 | surfactin | 82% | 
| Cluster 2 | terpene | 1,127,798 | 1,148,314 | ||
| Cluster 3 | NRPS | 1,557,678 | 1,624,493 | paenibacterin | 60% | 
| Cluster 4 | NRPS | 1,770,137 | 1,875,386 | bacillaene | 100% | 
| Cluster 5 | NRPS, betalactone | 1,969,943 | 2,047,024 | fengycin | 100% | 
| Cluster 6 | terpene | 2,119,954 | 2,141,852 | ||
| Cluster 7 | T3PKS | 2,318,835 | 2,359,932 | ||
| Cluster 8 | NRPS | 3,262,252 | 3,309,388 | bacillibactin | 100% | 
| Cluster 9 | CDPS | 3,592,205 | 3,612,951 | ||
| Cluster 10 | sactipeptide | 3,842,693 | 3,864,304 | subtilosin A | 100% | 
| Cluster 11 | other | 3,871,089 | 3,912,507 | bacilysin | 100% | 
Publisher’s Note: MDPI stays neutral with regard to jurisdictional claims in published maps and institutional affiliations.  | 
© 2022 by the authors. Licensee MDPI, Basel, Switzerland. This article is an open access article distributed under the terms and conditions of the Creative Commons Attribution (CC BY) license (https://creativecommons.org/licenses/by/4.0/).
Share and Cite
Xu, W.; Yang, Q.; Xie, X.; Goodwin, P.H.; Deng, X.; Zhang, J.; Sun, R.; Wang, Q.; Xia, M.; Wu, C.; et al. Genomic and Phenotypic Insights into the Potential of Bacillus subtilis YB-15 Isolated from Rhizosphere to Biocontrol against Crown Rot and Promote Growth of Wheat. Biology 2022, 11, 778. https://doi.org/10.3390/biology11050778
Xu W, Yang Q, Xie X, Goodwin PH, Deng X, Zhang J, Sun R, Wang Q, Xia M, Wu C, et al. Genomic and Phenotypic Insights into the Potential of Bacillus subtilis YB-15 Isolated from Rhizosphere to Biocontrol against Crown Rot and Promote Growth of Wheat. Biology. 2022; 11(5):778. https://doi.org/10.3390/biology11050778
Chicago/Turabian StyleXu, Wen, Qian Yang, Xia Xie, Paul H. Goodwin, Xiaoxu Deng, Jie Zhang, Runhong Sun, Qi Wang, Mingcong Xia, Chao Wu, and et al. 2022. "Genomic and Phenotypic Insights into the Potential of Bacillus subtilis YB-15 Isolated from Rhizosphere to Biocontrol against Crown Rot and Promote Growth of Wheat" Biology 11, no. 5: 778. https://doi.org/10.3390/biology11050778
APA StyleXu, W., Yang, Q., Xie, X., Goodwin, P. H., Deng, X., Zhang, J., Sun, R., Wang, Q., Xia, M., Wu, C., & Yang, L. (2022). Genomic and Phenotypic Insights into the Potential of Bacillus subtilis YB-15 Isolated from Rhizosphere to Biocontrol against Crown Rot and Promote Growth of Wheat. Biology, 11(5), 778. https://doi.org/10.3390/biology11050778
        
                                                